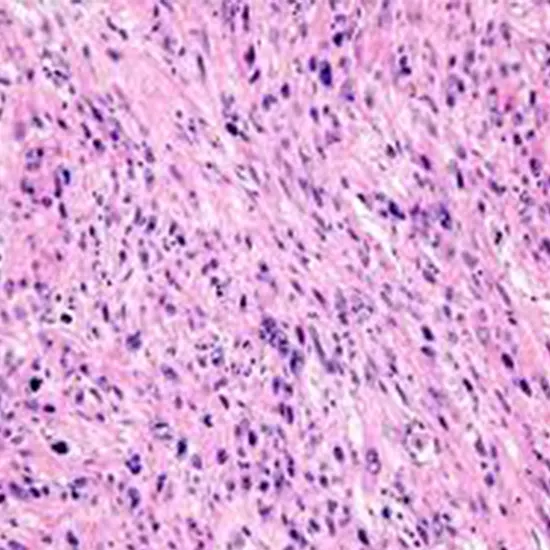
leiomyosarcoma test

Book Leiomyosarcoma Appointment Online Near me at the best price in Delhi/NCR from Ganesh Diagnostic. NABL & NABH Accredited Diagnostic centre and Pathology lab in Delhi offering a wide range of Radiology & Pathology tests. Get Free Ambulance & Free Home Sample collection. 24X7 Hour Open. Call Now at 011-47-444-444 to Book your Leiomyosarcoma at 50% Discount.
Leiomyosarcoma is a rare type of soft tissue cancer that arises from smooth muscle cells, which are involuntary muscles found in the walls of organs such as the uterus, gastrointestinal tract, blood vessels, and other soft tissues.
Leiomyosarcoma can occur in various parts of the body but is most commonly found in the uterus (referred to as uterine leiomyosarcoma) and in the gastrointestinal tract.
| CBC | 175 | |
| CA-125 | 600 | |
| LDH | 200 | |
| LFT | 300 | |
| Serum Electrolytes | 225 | |
| Serum Urea | 65 | |
| Ultrasound Whole Abdomen | 1000 | |
| MRI abdomen scan | 8000 | |
| Whole Body PET Scan | 11950 | |
| Total Price | 22515 |
The Symptoms of leiomyosarcoma may include Pain or discomfort, Palpable mass or lump, bleeding or abnormal discharge, etc. The diagnosis of leiomyosarcoma typically involves a combination of imaging studies such as MRI scans, CT scans, and/or PET scans, as well as a biopsy to confirm the presence of cancerous cells.
| Test Type | Leiomyosarcoma |
| Includes | Leiomyosarcoma (Common Diseases) |
| Preparation | |
| Reporting | Within 24 hours* |
| Test Price |
₹ 22515
|

Early check ups are always better than delayed ones. Safety, precaution & care is depicted from the several health checkups. Here, we present simple & comprehensive health packages for any kind of testing to ensure the early prescribed treatment to safeguard your health.